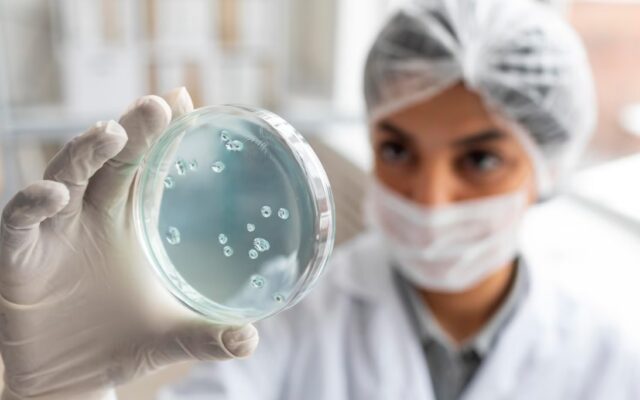

Przez tysiąclecia bylica roczna (Artemisia annua) była używana w Azji Południowo-Wschodniej do leczenia „gorączki”. Ta lecznicza roślina ma wiele zastosowań w kierunku zwalczania patogenów i stanowi źródło pochodnych artemizyny, które to stosowane są jako leki pierwszego rzutu w leczeniu malarii wywołanej przez pasożyty.
Pandemia SARS-CoV-2 (Covid-19) doprowadziła do śmierci milionów ludzi a także powstania wielu wariantów, spośród których największe zagrożenie stanowi wariant delta ze względu na największą zaraźliwość. Z tego powodu naukowcy postanowili sprawdzić skuteczność odmian bylicy rocznej przeciwko nowym wariantom.
W badaniu na liniach komórkowych Vero E6 mierzono skuteczność naparów przyrządzonych z suszonych odmian bylicy rocznej (A3, BUR, MED, SAM) przeciwko pięciu wariantom SARS-CoV-2: alpha, beta, gamma, delta oraz kappa.
Ekstrakty z bylicy okazały się skuteczne nie tylko wobec pierwotnego wariantu SARS-CoV-2 WA1 ale także wobec wszystkich pięciu nowych wariantów. Wyniki sugerują, że picie naparu z bylicy rocznej, może potencjalnie stanowić tanią terapię dla pacjentów chorych na Covid-19 i powstrzymywać rozprzestrzenianie się wirusa zanim pojawią się w pełni efektywne terapie. Autorzy badań zwrócili się do WHO by rozważyli włączenie ekstraktów i kapsułek zawierających suszone liście do już toczących się badań klinicznych nad artezunatem (lek przeciw malarii).
Nair MS, Huang Y, Fidock DA, Towler MJ, Weathers PJ. Artemisia annua L. hot-water extracts show potent activity in vitro against Covid-19 variants including delta. J Ethnopharmacol. 2022 Feb 10;284:114797. doi: 10.1016/j.jep.2021.114797. Epub 2021 Nov 1. PMID: 34737005; PMCID: PMC8559441.
Nair MS, Huang Y, Fidock DA, Polyak SJ, Wagoner J, Towler MJ, Weathers PJ. Artemisia annua L. extracts inhibit the in vitro replication of SARS-CoV-2 and two of its variants. J Ethnopharmacol. 2021 Jun 28;274:114016. doi: 10.1016/j.jep.2021.114016. Epub 2021 Mar 12. PMID: 33716085; PMCID: PMC7952131.